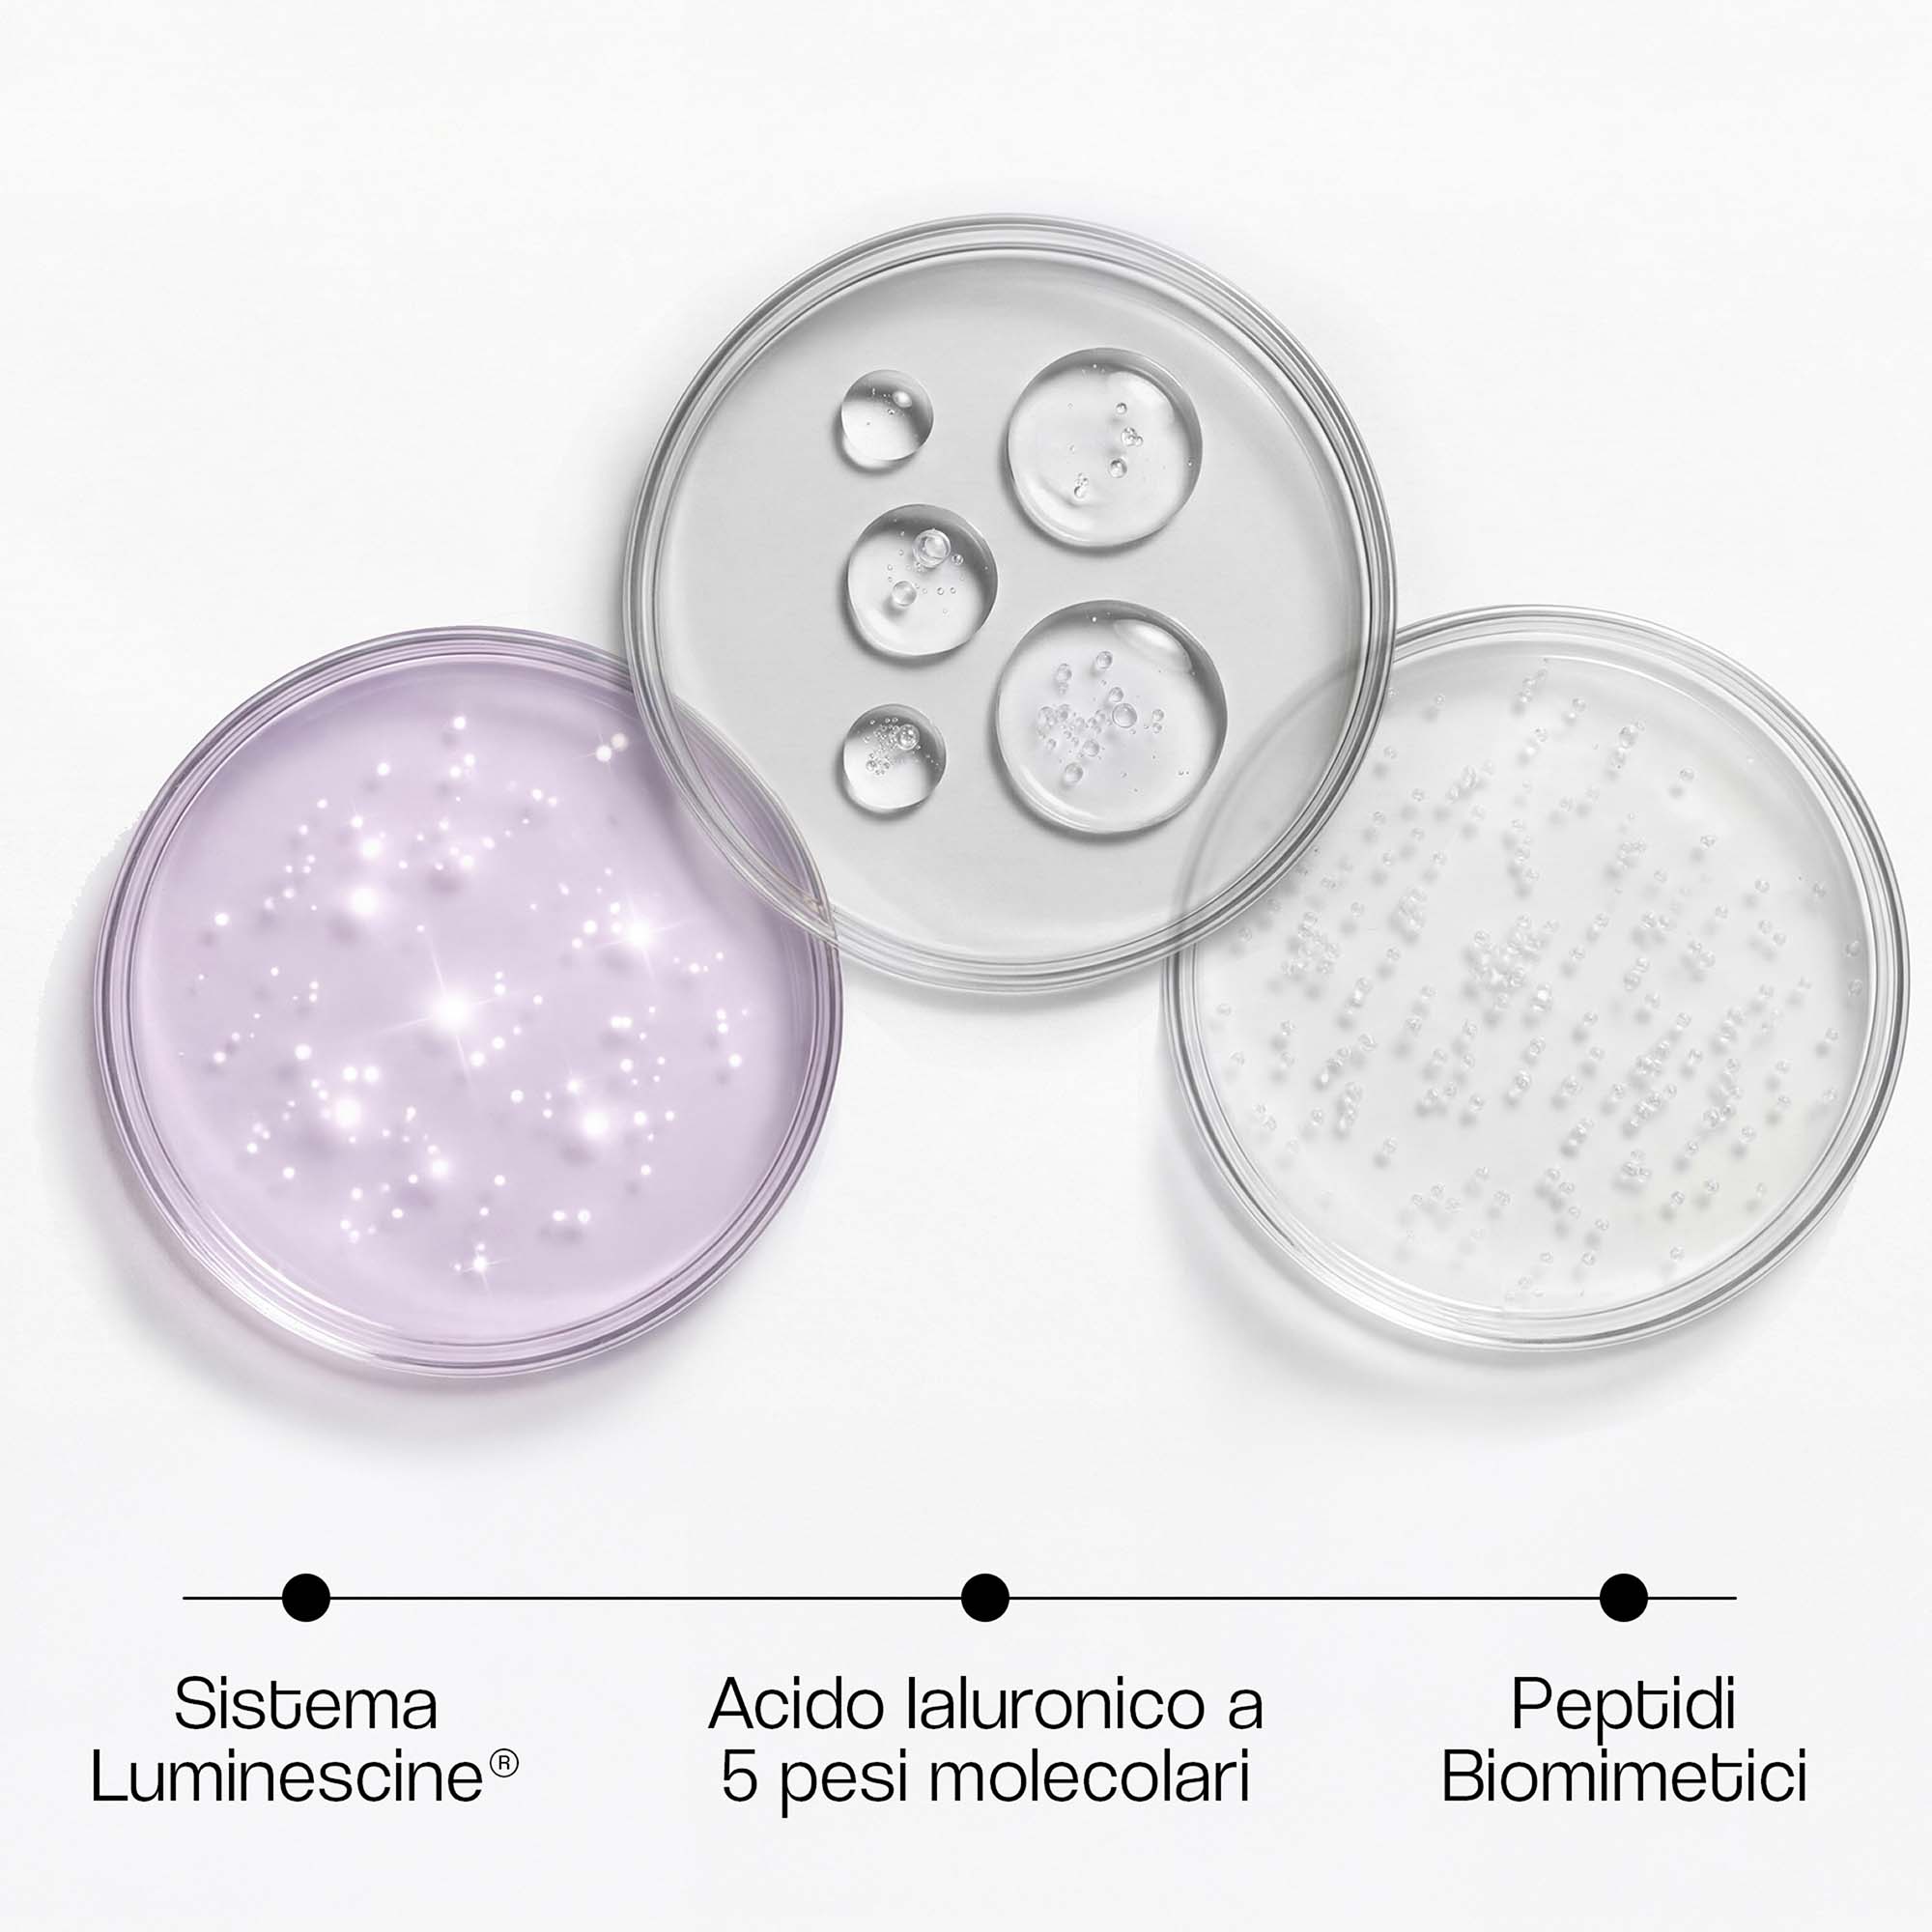
Visual ANTIOX ADVANCE con texture e ingredienti in vaschette

Skincare > ANTIOX ADVANCE
Siero Contorno Occhi
ANTIOX ADVANCE
ANTIOSSIDANTE
Con 5 Acidi Ialuronici, Peptidi Biomimetici Distensivi, Luminescine® e AsterVitis Oxy™
Il siero che protegge lo sguardo dallo stress ossidativo
Prima applicazione
Alla prima applicazione sentirai la zona del contorno occhi più morbida e idratata. La texture leggera si assorbe rapidamente e aiuta la pelle a ritrovare comfort e freschezza.
1 Settimana dopo
Dopo una settimana lo sguardo inizierà ad apparire più luminoso e riposato. L’azione combinata degli attivi contribuisce a sostenere l’equilibrio della pelle nella zona perioculare.
4 Settimane dopo
Dopo quattro settimane la pelle del contorno occhi apparirà più levigata e uniforme. L’utilizzo costante aiuta a migliorare la qualità della superficie cutanea, sostenendo idratazione, elasticità e protezione antiossidante.
ZONA DI TRATTAMENTO
Contorno occhi (zona perioculare)
TIPOLOGIA DI PRODOTTO
Siero
COMPATIBILITA' PELLE
Adatto a tutti i tipi di pelle della zona perioculare.
FUNZIONE COSMETICA
Supporto antiossidante, idratazione multilivello, miglioramento dell’aspetto di occhiaie e segni di stanchezza.
INGREDIENTI CHIAVE
Complesso antiossidante polifenolico, Sistema ialuronico multilivello, Luminescine®, Peptidi biomimetici distensivi.

MODALITA’
D’uso
01
Applicare una piccola quantità di siero sulla zona del contorno occhi mattina e sera, sulla pelle detersa. Distribuire il prodotto con movimenti delicati dall’interno verso l’esterno fino a completo assorbimento.
02
Testare il prodotto su una piccola parte prima dell’utilizzo.
03
Non utilizzare su cute lesa. Evitare il contatto diretto con gli occhi.

MODALITA’
D’uso
01
Applicare una piccola quantità di siero sulla zona del contorno occhi mattina e sera, sulla pelle detersa. Distribuire il prodotto con movimenti delicati dall’interno verso l’esterno fino a completo assorbimento.
02
Testare il prodotto su una piccola parte prima dell’utilizzo.
03
Non utilizzare su cute lesa. Evitare il contatto diretto con gli occhi.
Consigli per la routine
1
Applica Siero Revitalizzante BioVita C sulla pelle detersa per sostenere luminosità, idratazione ed energia cutanea.
2
Prosegui con Antiox Advance, indicato per la zona perioculare, naturalmente più sottile e delicata rispetto al resto del viso.
3
Completa la routine con Crema Nutriente Ristrutturante H24 SPF 30, che aiuta a nutrire la pelle di notte e a proteggerla dai raggi UV di giorno.
1
Applica Siero Revitalizzante BioVita C sulla pelle detersa per sostenere luminosità, idratazione ed energia cutanea.
2
Prosegui con Antiox Advance, indicato per la zona perioculare, naturalmente più sottile e delicata rispetto al resto del viso.
3
Completa la routine con Crema Nutriente Ristrutturante H24 SPF 30, che aiuta a nutrire la pelle di notte e a proteggerla dai raggi UV di giorno.
Gli elementi principali del
Siero contorno occhiANTIOX ADVANCE
SISTEMA IALURONICO A 5 FORME
(Sodium Hyaluronate High Molecular Weight, Sodium Hyaluronate Medium Molecular Weight, Sodium Hyaluronate Low Molecular Weight, Hydrolyzed Hyaluronic Acid, Sodium Hyaluronate Crosspolymer-3)
Il contorno occhi non richiede semplicemente più acido ialuronico, ma un sistema capace di lavorare su livelli differenti della superficie cutanea. Le frazioni ad alto peso molecolare contribuiscono a formare un film superficiale che aiuta a trattenere acqua e a migliorare immediatamente la morbidezza percepita. Le frazioni a medio e basso peso molecolare favoriscono una distribuzione più uniforme dell’idratazione negli strati superficiali dell’epidermide. La forma idrolizzata contribuisce a una diffusione più omogenea sulla micro-trama cutanea. Il crosspolymer reticolato agisce come serbatoio idrico, sostenendo nel tempo l’idratazione e migliorando la sensazione di elasticità. Questo approccio supera il concetto di semplice effetto filmogeno temporaneo, strutturando l’idratazione in modo stratificato e coerente con la fisiologia della zona perioculare.
PEPTIDI BIOMIMETICI DISTENSIVI
(Pentapeptide-18 + Acetyl Hexapeptide-8)
La zona perioculare è sottoposta a migliaia di micro-movimenti quotidiani legati alla mimica. Le linee sottili che compaiono non sono esclusivamente legate alla disidratazione, ma anche alla componente dinamica. I peptidi biomimetici presenti in formula sono progettati per imitare specifici meccanismi biologici, contribuendo a modulare l’aspetto delle linee di espressione. Il loro intervento è cosmetico e funzionale: non riempiono, ma supportano visivamente un aspetto più disteso della superficie cutanea, nel rispetto della naturale mobilità dell’area perioculare.
SISTEMA ILLUMINANTE CON LUMINESCINE®
(Hydrolyzed Verbascum Thapsus Flower Extract)
Nel contorno occhi la percezione di freschezza e vitalità è fortemente legata alla qualità della riflessione della luce. Luminescine® è un attivo di origine vegetale studiato per contribuire a migliorare la luminosità ottica della pelle, favorendo una riflessione della luce più uniforme. In un’area sottile e facilmente soggetta a disomogeneità visive, questo significa uno sguardo che appare più fresco e visivamente più uniforme.
SISTEMA IALURONICO A 5 FORME
(Sodium Hyaluronate High Molecular Weight, Sodium Hyaluronate Medium Molecular Weight, Sodium Hyaluronate Low Molecular Weight, Hydrolyzed Hyaluronic Acid, Sodium Hyaluronate Crosspolymer-3)
Il contorno occhi non richiede semplicemente più acido ialuronico, ma un sistema capace di lavorare su livelli differenti della superficie cutanea. Le frazioni ad alto peso molecolare contribuiscono a formare un film superficiale che aiuta a trattenere acqua e a migliorare immediatamente la morbidezza percepita. Le frazioni a medio e basso peso molecolare favoriscono una distribuzione più uniforme dell’idratazione negli strati superficiali dell’epidermide. La forma idrolizzata contribuisce a una diffusione più omogenea sulla micro-trama cutanea. Il crosspolymer reticolato agisce come serbatoio idrico, sostenendo nel tempo l’idratazione e migliorando la sensazione di elasticità. Questo approccio supera il concetto di semplice effetto filmogeno temporaneo, strutturando l’idratazione in modo stratificato e coerente con la fisiologia della zona perioculare.
PEPTIDI BIOMIMETICI DISTENSIVI
(Pentapeptide-18 + Acetyl Hexapeptide-8)
La zona perioculare è sottoposta a migliaia di micro-movimenti quotidiani legati alla mimica. Le linee sottili che compaiono non sono esclusivamente legate alla disidratazione, ma anche alla componente dinamica. I peptidi biomimetici presenti in formula sono progettati per imitare specifici meccanismi biologici, contribuendo a modulare l’aspetto delle linee di espressione. Il loro intervento è cosmetico e funzionale: non riempiono, ma supportano visivamente un aspetto più disteso della superficie cutanea, nel rispetto della naturale mobilità dell’area perioculare.
SISTEMA ILLUMINANTE CON LUMINESCINE®
(Hydrolyzed Verbascum Thapsus Flower Extract)
Nel contorno occhi la percezione di freschezza e vitalità è fortemente legata alla qualità della riflessione della luce. Luminescine® è un attivo di origine vegetale studiato per contribuire a migliorare la luminosità ottica della pelle, favorendo una riflessione della luce più uniforme. In un’area sottile e facilmente soggetta a disomogeneità visive, questo significa uno sguardo che appare più fresco e visivamente più uniforme.
FAQ
Il siero può essere applicato mattina e sera sulla pelle detersa, dopo il siero viso e prima della crema viso. È sufficiente una piccola quantità per la zona del contorno occhi.
La formula è progettata per essere compatibile con tutti i tipi di pelle, anche nella zona perioculare naturalmente più delicata. In caso di pelle particolarmente sensibile è consigliabile iniziare con applicazioni graduali.
La zona perioculare è molto sensibile a stress, affaticamento e fattori ambientali. Gli attivi antiossidanti, idratanti e illuminanti della formula contribuiscono a migliorare l’aspetto della pelle e a rendere lo sguardo progressivamente più fresco e luminoso.
Sì. Antiox Advance può essere inserito all’interno della routine cosmetica insieme agli altri prodotti della linea FlowLab Pharma. Si consiglia l’utilizzo dopo il siero viso BioVita C e prima della Crema Viso Ristrutturante H24 SPF 30.